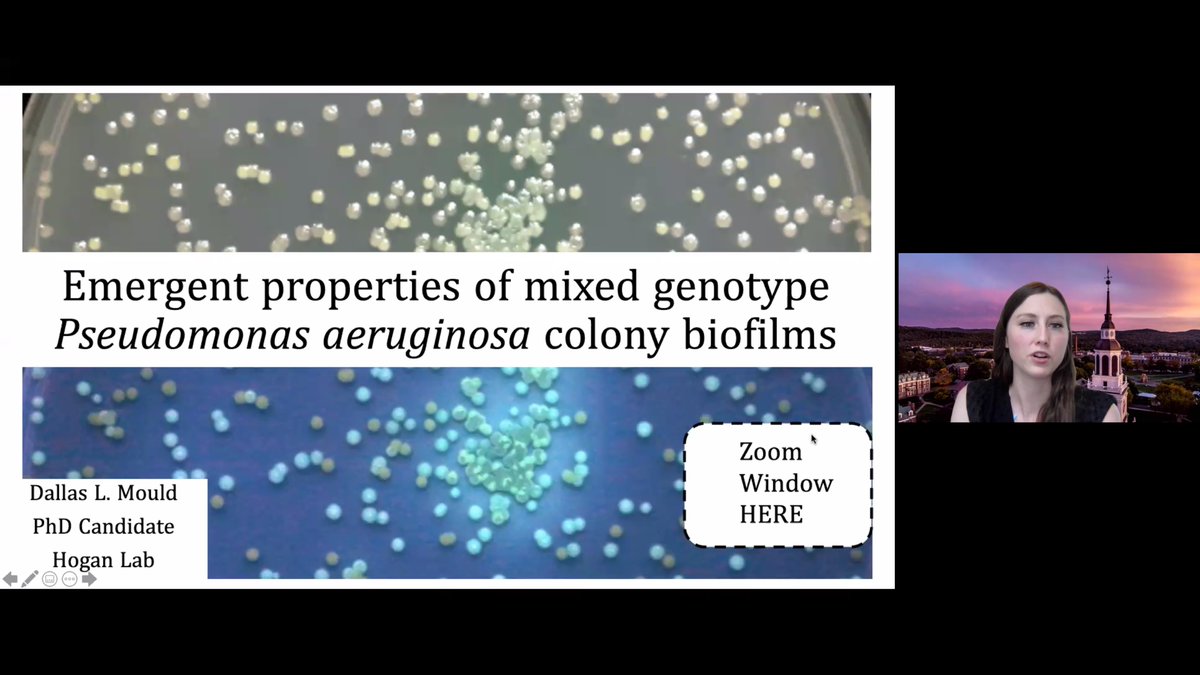
<a href="/MouldDMicrobe/">Dallas L. Mould</a> (from <a href="/thehoganlab/">Deborah Hogan</a>) on the emergent properties of mixed genotype Pseudomonas 
aeruginosa colony biofilms
#biofilms2020

Georgia Doing
@doingmicrobio
PhD candidate in @thehoganlab interrogating microbial interactions using the leverage of big data computational biology
ID: 1255875823711801344
30-04-2020 15:05:14
22 Tweet
87 Takipçi
124 Takip Edilen


We just posted a new manuscript on BioRxiv describing a second large biofilm adhesin in P. fluorescens. Turns out that multiple Pseudomonads and other gammaproteobacteria have more than one! biorxiv.org/content/10.110… Alan Collins Dr. Alexander Pastora @tjarrods

Dallas L. Mould (from Deborah Hogan) on the emergent properties of mixed genotype Pseudomonas aeruginosa colony biofilms #biofilms2020

Conditional antagonism in co-cultures of Pseudomonas aeruginosa and Candida albicans: An intersection of ethanol and phosphate signaling distilled from dual-seq transcriptomics -in PLOS Genetics from Deborah Hogan journals.plos.org/plosgenetics/a…



First grad school publication! Could not have done it without the amazing support and guidance from Casey Greene and all the members of Greene Laboratory - I feel very lucky to be apart of such a wonderful lab!

Excited for day 2 of #biodata20 CSHL Meetings! I am sharing a poster on deep learning modeling of Pseudomonas aeruginosa (P.a.) gene expression and a case-study of ex vivo sputum with co-authors Alexandra Lee (@[email protected]) dinosaur @microbigal_phd Casey Greene Deborah Hogan


Well-spoken killer whales and eye tricks exposed! Join Dartmouth GSC, Alberto Ruiz and I at a virtual Science on Tap tomorrow at 6. Come one, come all! facebook.com/DartmouthGSC/p…




Awesome micro interactions talks! Special shout-out to Dallas L. Mould who keeps changing hearts and minds 🧬🧪🔬🧫😍🤯

New pre-print on the mechanisms for and importance of interspecies and intraspecies cross-feeding in Pseudomonas aerguinosa in biorxiv.org/cgi/content/sh… by Dallas L. Mould and other Hogan Lab colleagues.